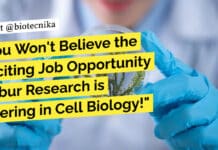
You Won’t Believe the Exciting Job Opportunity Dabur Research is Offering in Cell Biology! Dabur Research Foundation Jobs - MSc, PhD Biotech, Biochem, Biology Apply

Exciting Opportunity at Ocugen: QA Manager / Sr. QA Specialist Wanted for Life-Changing Projects!
Quality Assurance Manager / Sr. Quality Assurance Specialist at Ocugen
About Ocugen
Ocugen is a leading biopharmaceutical company focused on developing novel treatments for various diseases....
You Won’t Believe the Exciting Job Opportunity Dabur Research is Offering in Cell Biology!
Dabur Research Foundation Jobs - MSc, PhD Biotech, Biochem, Biology Apply
Dabur Research Foundation Jobs - MSc, PhD Biotech, Biochem, Biology Apply. MSc & PhD...
ICAB-2023 – International Conference on Advances in Biotechnology: Current Discoveries and Future Perspectives
ICAB-2023 - International Conference on Advances in Biotechnology: Current Discoveries and Future Perspectives
About
Amity University Mumbai
Amity University Mumbai has been established under Maharashtra Govt. Act...
Apply Now for a Job as Project Associate-I/JRF at a Prestigious Research Institute!
DY Patil Pune JRF Jobs For MSc, MTech Biotech, Biological & Life Sciences
DY Patil Pune JRF Jobs For MSc, MTech Biotech, Biological & Life...
Unveiling the Oldest Known Vertebrate Skull – Discoveries That Will Revolutionize Our Understanding of...
Exploring the Oldest Known Vertebrate Skull: An Evolutionary Analysis
The skull is an incredibly complex structure in the vertebrate skeleton, with a wide range of...
AstraZeneca’s Game-Changing ‘Carbon Negative’ Biotech Building in Amsterdam Will Revolutionize Sustainability in the Industry!”
AstraZeneca has recently approved the construction of a new biotech building in Amsterdam that is set to be 'carbon negative'. This exciting development comes...
Find out how this startup raised $16.1 million to revolutionize cell therapy using machine...
JURA Bio, a new startup founded by Elizabeth Wood, aims to bring machine learning (ML) to the field of cell therapy. The company recently...
Top Universities in Europe: UK Dominates QS Rankings 2024, Oxford Claims First Place
QS World University Rankings!
The QS World University Rankings for Europe in 2024 are out! They evaluate 688 universities in Europe based on 12 categories,...
Grab Your Chance! JRF Job at Prestigious NIPER – Walk-in-Interview Details Inside!
JRF Job NIPER Biotech, Biochem & Microbiology - Attend Walk-In
National Institute of Pharmaceutical Education & Research (NIPER)
NIPER is a prestigious institute under the Department...
Exciting Job Opportunity: 1065 Lecturer Positions in Staff Selection Board – Apply Now!
SSB Odisha Recruitment 2023 - Lecturer Positions Available
Staff Selection Board
We are pleased to announce the recruitment of 1065 Lecturers (Direct Payment Posts) in different...
Unleash Your Potential as a Field Operations Executive at Rentokil Initial UK – Apply...
Job Posting: Field Operations Executive at Rentokil Initial UK
Rentokil Initial PCI is the leading pest control service provider in India. A joint venture between...
Discover Your Dream Job as a Food Technologist at Prolicious – Join the Exciting...
Prolicious Food Technology Job - MSc, BTech & MTech Apply
Job Posting: Food Technologist at Prolicious
About Prolicious
Prolicious is a leading food manufacturing company based in...
Discover an Exciting JRF Job Opportunity at TNJFU – Apply Now!
JRF Job at TNFJU - Applications Invited
Job Title: JRF Job at TNJFU
About the Institute
The Tamil Nadu Dr. J. Jayalalithaa Fisheries University (TNJFU) is a...
Want to Make a Difference in the Pharma Industry? Apply Now for the Associate...
Novartis Biology Job - MSc & BSc Candidates Apply
Job Posting: Associate at Novartis
Novartis is a global pharmaceutical company committed to improving the lives of...
Breaking: Dream Research Fellow Position Available at Renowned Institution of BITS Pilaniy Now!
BITS Pilani JRF Vacancy For MSc, MTech Biotech, Botany & Biological Sciences
BITS Pilani JRF Vacancy For MSc, MTech Biotech, Botany & Biological Sciences. Interested...